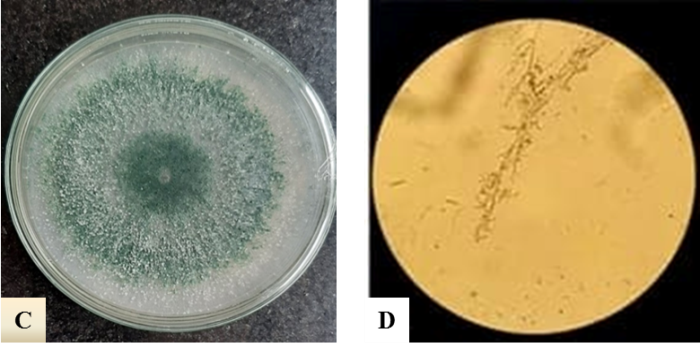
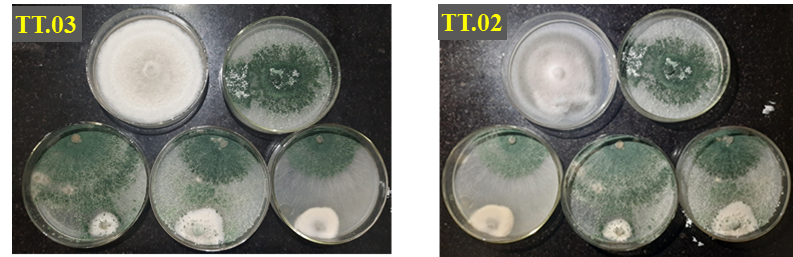

Tin hoạt động
Tuyển chọn nấm Trichoderma spp. có khả năng đối kháng với tác nhân gây bệnh thán thư trên cây xoài
Ở Việt Nam, xoài được trồng từ Nam chí Bắc, vùng trồng xoài tập trung từ Bình Định trở vào và được trồng nhiều nhất ở các tỉnh Đồng bằng Sông Cửu Long. Hiện tại, bộ giống xoài rất đa dạng với 46 giống loài, sản lượng năm 2019 đạt 31.276 tấn đã giúp Việt Nam đứng thứ 13 về sản xuất xoài trên thế giới. Với tiềm năng xuất khẩu các loại trái cây chủ lực của Việt Nam, việc đảm bảo chất lượng cần được ưu tiên hàng đầu. Chính vì thế việc chăm sóc phòng trừ bệnh hại đối với các cây ăn quả là điều phải quan tâm. Một trong những bệnh thường gặp ở cây ăn quả gây ảnh hưởng nghiêm trọng đến chất lượng quả là bệnh thán thư.
Bệnh thán thư là một trong những bệnh hại nguy hiểm đối với cây ăn quả và phổ biến ở vùng nhiệt đới và cận nhiệt đới, do nấm Colletotrichum spp. gây ra. Loài nấm bệnh này gây hại trên nhiều loại cây trồng khác, làm giảm giá trị kinh tế, gây thiệt hại nặng nề cho người nông dân. Trong đó, xoài là cây ăn quả bị bệnh thán thư gây hại phổ biến và nặng nề nhất. Bệnh làm cho lá rụng hàng loạt, hầu hết các chùm hoa đều bị rụng, quả non cũng bị rụng, quả lớn bị thối. Để hạn chế bệnh hại người dân thường dùng các loại thuốc hóa học và điều này đã gây ra ô nhiễm môi trường, ảnh hưởng đến sức khỏe của con người. Vì vậy, các biện pháp kiểm soát sinh học đang được sử dụng rộng rãi ở Việt Nam và trên thế giới để hướng tới nền nông nghiệp sạch và an toàn.

Hình 1. Bệnh thán thư trên cây xoài (Sưu tầm)
Trong số các tác nhân sinh học, nấm Trichoderma spp. được sử dụng nhiều để kiểm soát bệnh hại cây trồng, trong đó có bệnh thán thư. Tại Việt Nam, cũng có nhiều nghiên cứu về hoạt lực đối kháng của nấm Trichoderma với các loại nấm gây bệnh có trong đất, nhưng chưa có nhiều nghiên cứu với nấm gây bệnh thán thư. Chính vì vậy, nhóm tác giả Viện Di truyền Nông nghiệp, Học viện Nông nghiệp Việt Nam đã tiến hành nghiên cứu nhằm phân lập nấm Trichoderma spp. từ các mẫu đất vùng trồng xoài ở Đồng bằng sông Cửu Long dựa vào các đặc điểm hình thái kết hợp với giải trình tự gen vùng rDNA-ITS và tuyển chọn thông qua đánh giá họat tính đối kháng với tác nhân gây bệnh thán thư (C. gloeosporioides) trên cây xoài trong điều kiện in vitro và nhà lưới.
Quan sát các mẫu nấm Trichoderma spp. trên môi trường PDA cho thấy, lúc đầu tản nấm có màu trắng, hơi xốp và hình thành cành bào tử phân sinh. Sau 2 ngày nuôi cấy, tản nấm chuyển dần sang màu xanh, hình thành nhiều cành bào tử phân sinh. Bào tử phân sinh của nấm có dạng hình cầu hoặc hình trứng, bề mặt nhẵn. Thể bình có dạng hình trụ. Đa số các mẫu thu thập được hình thành nhiều bào tử phân sinh, sau 3 ngày nuôi cấy và đến ngày thứ 4 và thứ 5 thì nấm mọc kín đĩa và chuyển màu xanh hoàn toàn.

Chú thích: A, C: Tản nấm Trichoderma spp. trên môi trường PDA sau 5 ngày nuôi cấy; B, D: Cành bào tử và bào tử phân sinh nấm Trichoderma spp.
Hình 2. Đặc điểm hình thái và bào tử nấm Trichoderma spp.
Các chủng nấm Trichoderma spp. có hoạt tính đối kháng cao sẽ được tuyển chọn để sản xuất chế phẩm sinh học ứng dụng trong kiểm soát bệnh thán thư ngoài đồng ruộng. Kết quả của nghiên cứu này sẽ là tiền đề cho việc ứng dụng trong thực tế sản xuất. Khi xử lý chế phẩm có chủng nấm Trichoderma spp. ngoài đồng ruộng thì nên xử lý hoặc bón vào đất trước khi gieo hạt/trồng cây 2-3 ngày hoặc phun lên tán lá khi chưa hoặc vừa có dấu hiệu bệnh. Nấm Trichoderma sẽ phát triển và ngăn chặn nấm gây bệnh khi hạt được gieo, cây được trồng vào đất hoặc lá vừa chớm bệnh sẽ cho hiệu quả phòng trừ bệnh cao hơn.
Chú thích: Từ trên xuống dưới, trừ trái qua phải: A đối chứng nấm Colletotrichum (TT.03 và TT.02), đối chứng nấm Trichoderma (Tr.X2), nấm Trichoderma cấy trước nấm Colletotrichum 24 giờ, nấm Trichoderma cấy cùng nấm Colletotrichum, nấm Trichoderma cấy sau nấm Colletotrichum 24 giờ
Hình 3. Hoạt tính đối kháng của nấm Trichoderma Tr.X2 với nấm gây bệnh thán thư Colletotrichum asianum TT.03 và TT.02 ở các thời gian nuôi cấy khác nhau
Qua nghiên cứu cho thấy, đã phân lập và tuyển chọn được 14 chủng nấm Trichoderma spp. phân bố chủ yếu ở Đồng bằng sông Cửu Long, có khả năng đối kháng cao với nấm gây bệnh thán thư, trong đó có 6 chủng Tr.X1, Tr.X2, Tr.X3, Tr.X4, T1, M2 có hoạt tính cao nhất từ 77,76% – 86,25% trong điều kiện invitro và 41,1% – 75,3% trong điều kiện nhà lưới. Khi nuôi cấy nấm Trichoderma spp. trước nấm bệnh Colletotrichum asianum 24 giờ cho hiệu quả đối kháng cao hơn so với cấy cùng và cấy sau. Nấm Trichoderma Tr.X2 và Tr.X3 có khả năng ức chế tốt nấm gây bệnh thán thư Colletotrichum asianum trên cây xoài (hiệu quả đối kháng với nấm gây bệnh là 75,3% và 72,01%). Hai chủng nấm đối kháng tiềm năng Trichoderma Tr.X2 thuộc loài Trichoderma harzianum và Tr.X3 thuộc loài Trichoderma asperellum.
Link thông tin bài viết truy cập tại: http://tapchi.vnua.edu.vn/wp-content/uploads/2021/11/tap-chi-so-12.2.6.pdf
Đào Hương – NXB Học viện

